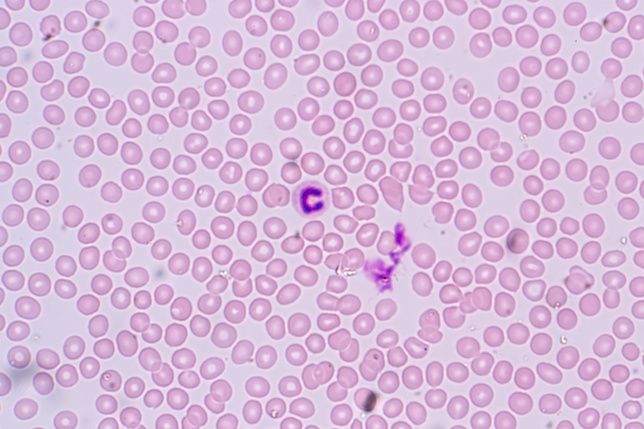

Zydelig (idelalisib) is a kinase inhibitor approved in 2014 for 3 oncology indications.


Zydelig (idelalisib) is a kinase inhibitor approved in 2014 for 3 oncology indications.

Trial identifies no new safety signals, as emicizumab continues to demonstrate effective bleeding control with a high proportion of participants achieving zero treated bleeds.

Heparin, a blood thinner given regularly at a low dose to hospitalized patients, helps to stop clots from forming and reduces inflammation.

Brexucabtagene autoleucel (Tecartus, Kite Pharma) is a cell-based gene therapy for the treatment of adult patients with mantle cell lymphoma who have not responded to or who have relapsed following other treatments.

The trial has successfully enrolled 17 patients with clear cell renal cell carcinoma and has reported that the drug is well tolerated at doses of up to 525 mg weekly.

Despite the encouraging progression-free survival findings, data on overall survival resulted in a partial clinical hold instituted by the FDA.

Results from the APOLLO trial showed a significant 37% reduction in the risk of progression or death, compared to pomalidomide and dexamethasone alone in patients with multiple myeloma.

The drug is approved for patients after 4 or more failed lines of therapy, although many patients in clinical trials had received 7 or more prior lines of therapy.

The 5-year overall survival was 18% in the CPX-351 group compared to 8% in the standard chemotherapy group.

Two studies by the University of Colorado Cancer Center provided an analysis for the theory of adaptive oncogenesis.

Asparaginase erwinia chrysanthemi (recombinant)-rywn) (Rylaze; Jazz Pharmaceuticals) provides a new alternative for a therapy in long-standing global shortage.

Umbralisib was granted accelerated approval by the FDA for the treatment of select patients with relapsed/refractory marginal zone lymphoma and relapsed/refractory follicular lymphoma.

The use of high throughput technologies has revolutionized the understanding of the cancer genome.

Orelabrutinib is a highly selective Bruton's tyrosine kinase inhibitor designed to target B-cell lymphomas and autoimmune indications.

Trilaciclib (Cosela) is indicated to reduce the frequency of chemotherapy-induced bone marrow suppression in adults receiving certain types of chemotherapy for extensive-stage small cell lung cancer.

Novel treatments and recent data about new drugs were presented at the first conference of Advanced Topics for Oncology Pharmacy Professionals (ATOPP).

The small-molecule inhibitors of the SOX 11 oncogene showed promise both as single agents and in combination with ibrutinib.

Azacitidine (Onureg) was approved by the FDA in September 2020 as a maintenance therapy for acute myeloid leukemia.

Results from the LOTIS-2 and LOTIS-3 trials show durable responses and a manageable toxicity profile among patients with both diffuse large B-cell lymphoma and mantle cell lymphoma treated with loncastuximab tesirine-lpyl (Zynlonta).

The demand for drug treatments in Europe and North American has increased in recent years, as awareness of the bleeding disorder rises.

The FDA also approved dabigatran etexilate oral pellets for the prevention of recurrent clots in patients aged 3 months to less than 12 years of age who have completed treatment for their first venous thromboembolism.

Pharmacists can educate patients about a pair of new treatment options for multiple myeloma approved by the FDA in March 2021.

The findings led to the FDA accepting the supplemental Biologics License Application and Priority Review designation for treatment, according to a Gilead press release.

Avapritinib is approved for adult patients with advanced systemic mastocytosis, including individuals with aggressive systemic mastocytosis, systemic mastocytosis with an associated hematological neoplasm, and mast cell leukemia.
Updated research offers an additional 2 years of follow-up data and statistics on treatment with a combination of ibrutinib and venetoclax in patients with chronic lymphocytic leukemia.